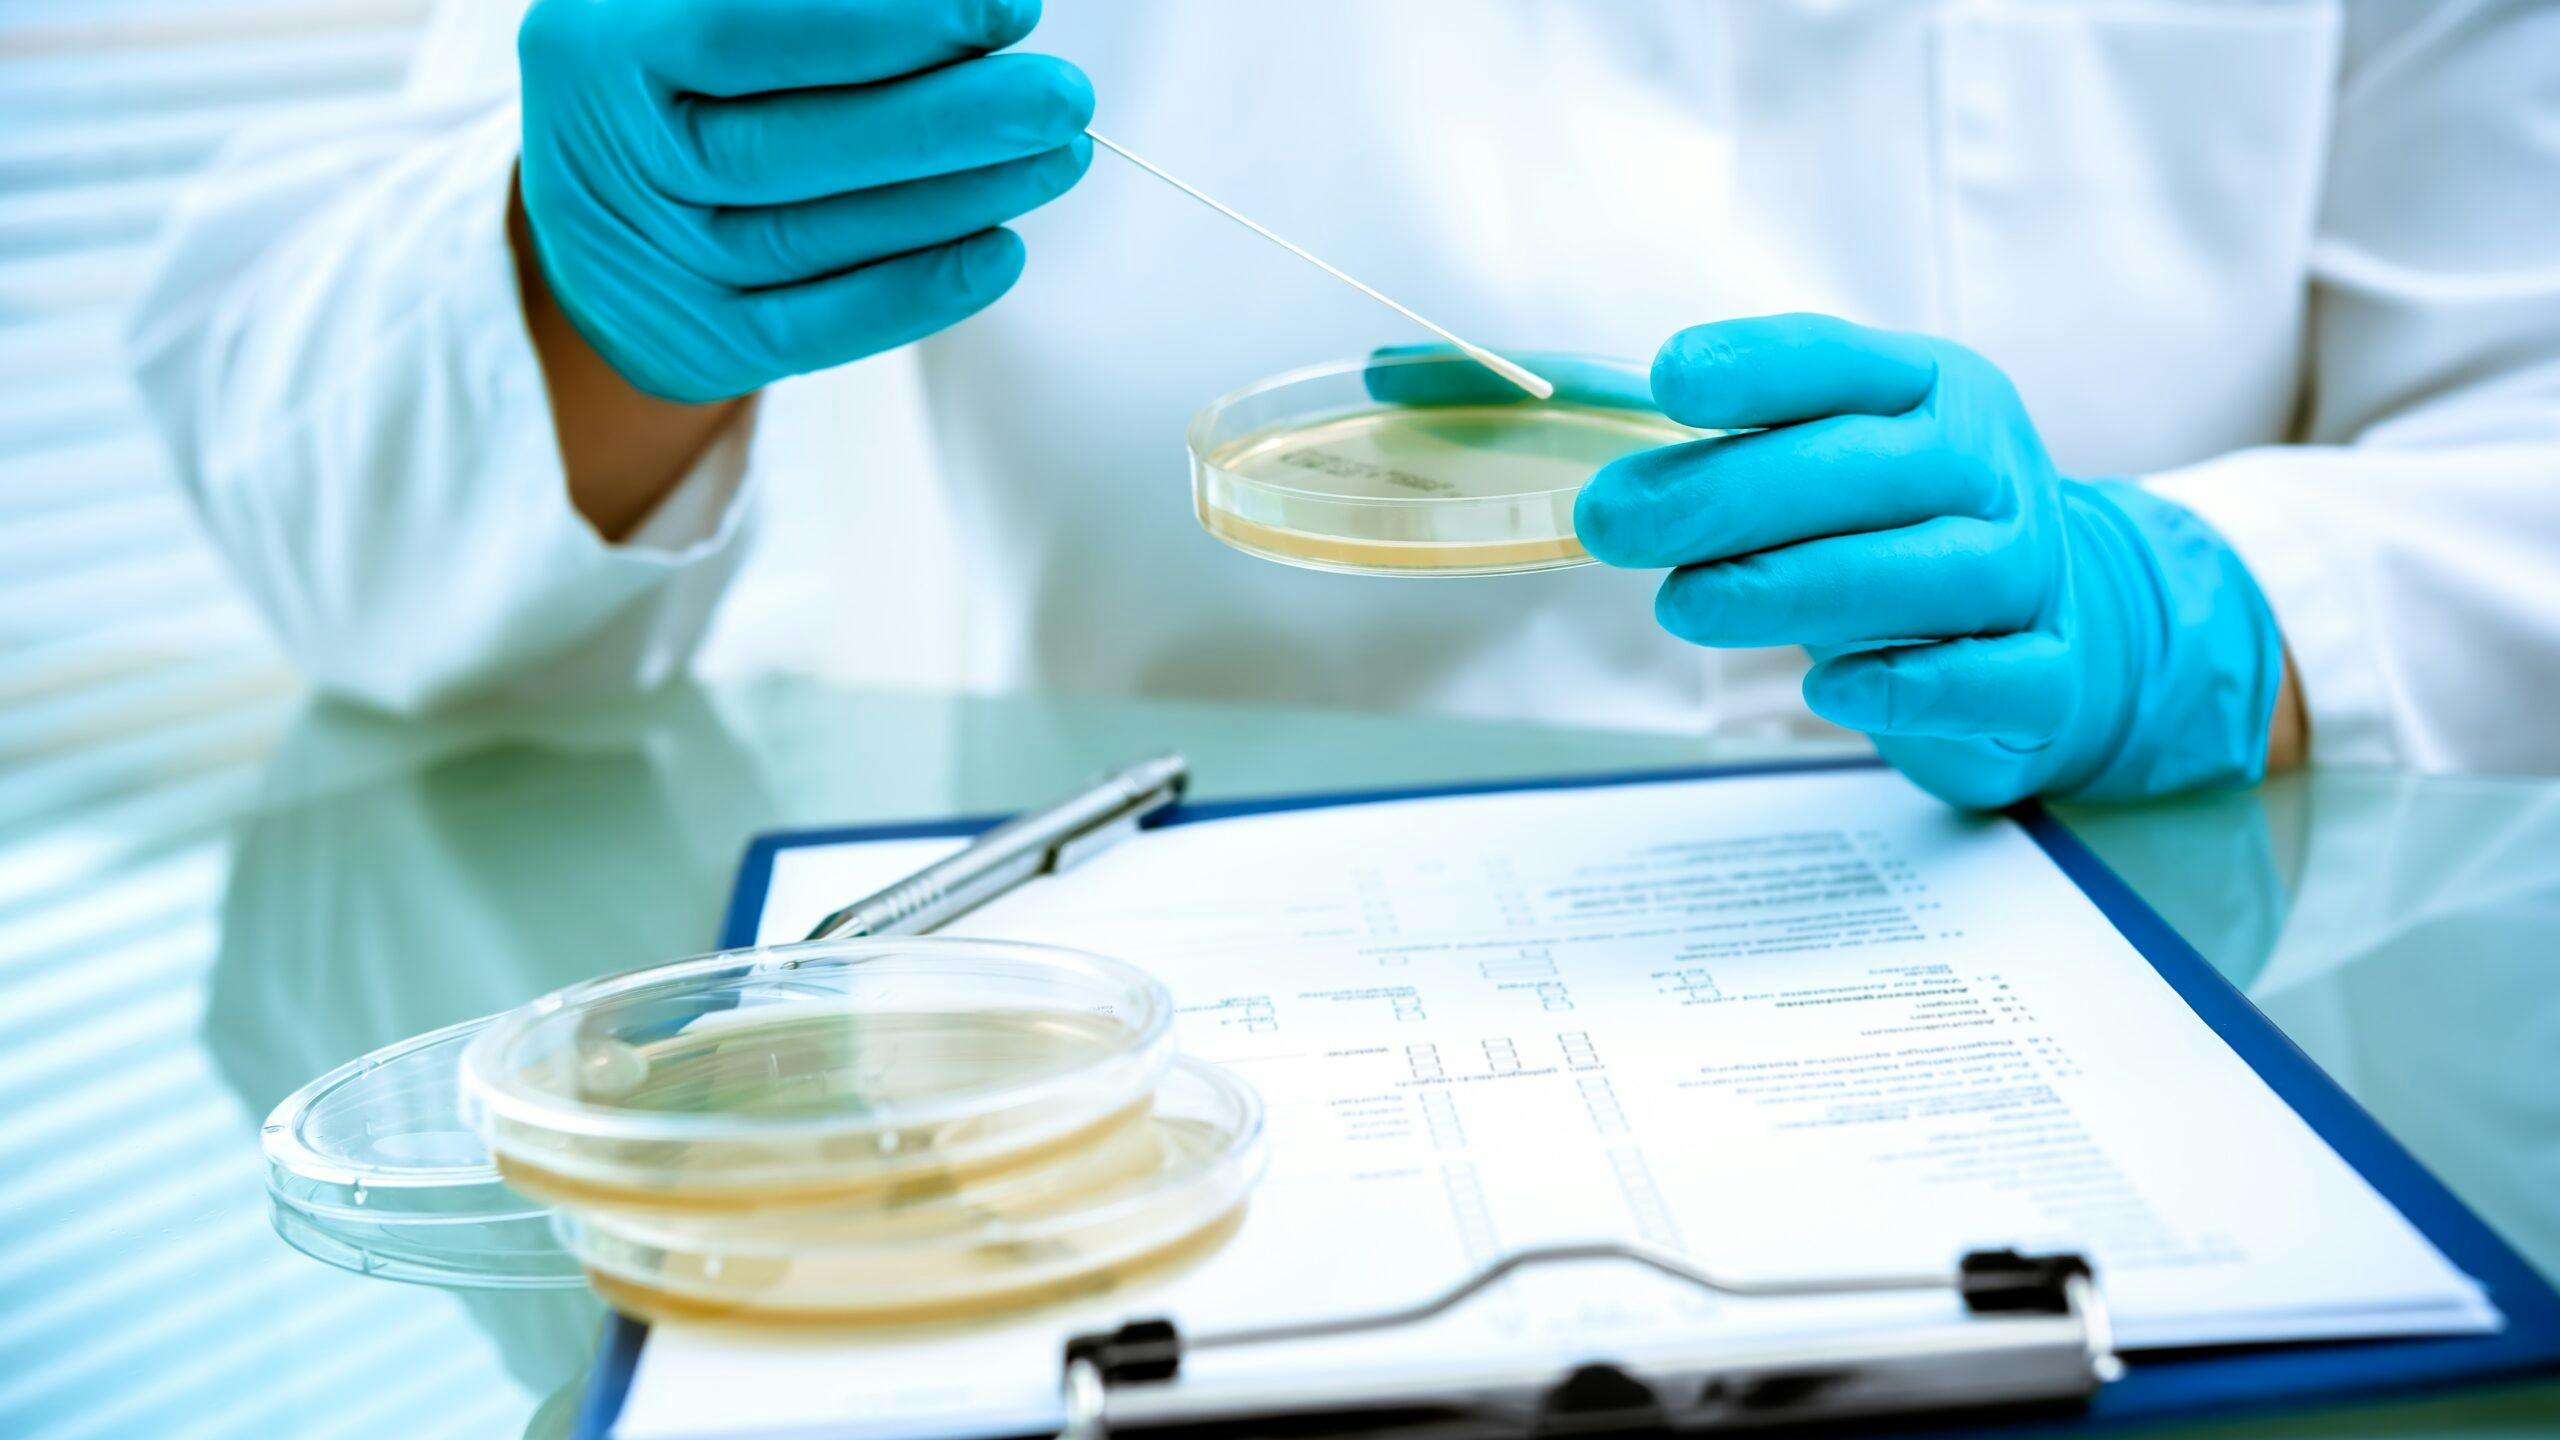
Beeld: Shutterstock

Voor abonnees Retail zet druk op leveranciers: in 5 stappen voorbereid op SBTi
Steeds meer voedselproducenten krijgen vragen van afnemers over hun klimaatbeleid. Dat komt niet uit de lucht vallen. Retailers zoals Albert Heijn, Lidl, Jumbo en Delhaize hebben zich gecommitteerd aan het Science Based Targets initiative (SBTi) en verwachten nu hetzelfde van hun leveranciers. Het initiatief is allesbehalve eenvoudig. In dit artikel vijf stappen ter voorbereiding.